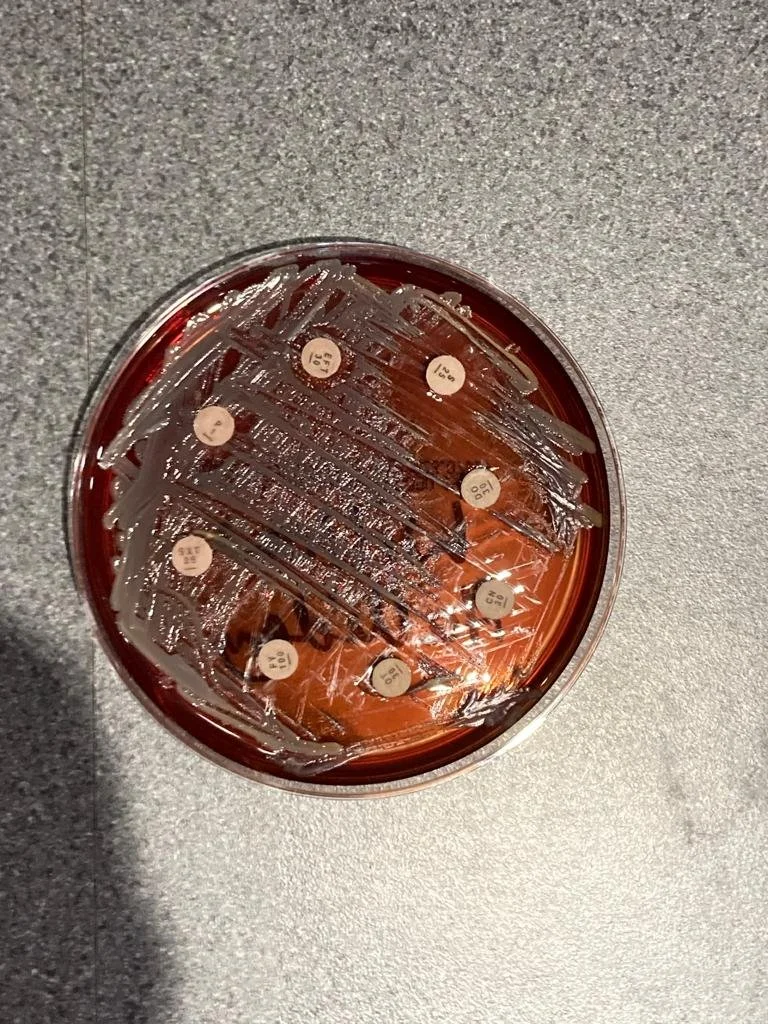
lab3jpeg.jpeg

CLINIC FACILITIES
Inpatient boxes
Stocks
Examination room
Arena
Post and Rail Fenced paddocks
Laboratory Work
Our in-house laboratory means we can analyse blood and other samples, usually with same day results. Many of our tests can also be run patient-side on the yard, allowing on-the-spot diagnostics and information to guide treatment plans.